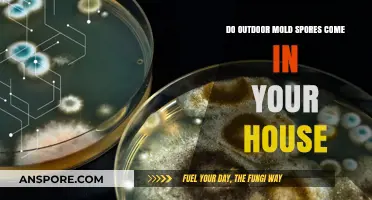
Outdoor Mold Spores Indoors: How They Enter and Impact Your Home

Petunias, beloved for their vibrant blooms and versatility in gardens, are flowering plants that reproduce primarily through seeds. Unlike ferns or fungi, which rely on spores for reproduction, petunias belong to the Solanaceae family and follow a typical angiosperm life cycle. Their seeds are produced within the flower’s ovary after pollination, often facilitated by insects or wind. While spores are a characteristic of non-seed plants and some fungi, petunias do not produce spores at any stage of their life cycle. Instead, their propagation is achieved through seeds, cuttings, or hybridization, making them a popular choice for gardeners seeking colorful, easy-to-grow annuals.
| Characteristics | Values |
|---|---|
| Do Petunias Have Spores? | No |
| Reproduction Method | Seeds |
| Plant Type | Angiosperm (Flowering Plant) |
| Family | Solanaceae (Nightshade Family) |
| Genus | Petunia |
| Pollination | Insect-pollinated (primarily bees and butterflies) |
| Seed Dispersal | Wind and animals |
| Life Cycle | Annual (completes life cycle in one growing season) |
| Propagation | Seeds, cuttings |
| Spores Presence | Absent (petunias do not produce spores) |
| Related Plants with Spores | Ferns, mosses, fungi (not petunias) |
Explore related products
What You'll Learn
- Petunia Reproduction Methods: Petunias reproduce via seeds, not spores, unlike ferns or fungi
- Seed vs. Spore Differences: Seeds contain embryos; spores are single-celled reproductive units
- Petunia Life Cycle: Petunias grow from seeds, flower, and produce new seeds annually
- Spores in Plants: Spores are common in non-flowering plants like mosses and ferns
- Why Petunias Lack Spores: Petunias are angiosperms, relying on seeds for propagation, not spores?

Petunia Reproduction Methods: Petunias reproduce via seeds, not spores, unlike ferns or fungi
Petunias, those vibrant blooms gracing gardens and balconies, rely on seeds for their continuation, not spores. This fundamental distinction sets them apart from ferns and fungi, which propagate through microscopic, single-celled spores dispersed by wind or water. Understanding this difference is crucial for gardeners aiming to cultivate healthy petunias, as it dictates the care and propagation techniques required.
While spores are lightweight and travel vast distances, petunia seeds are larger, requiring direct sowing or careful handling for successful germination. This reliance on seeds means petunias are more susceptible to environmental factors like soil quality and moisture levels during their early stages.
To successfully grow petunias from seed, start by sowing them indoors 8-10 weeks before the last frost date in your region. Use a well-draining seed starting mix and maintain a consistent temperature of around 70°F (21°C). Keep the soil moist but not soggy, as excessive moisture can lead to damping off, a fungal disease that affects seedlings. Once the seedlings have developed their first true leaves, transplant them into individual pots and gradually acclimate them to outdoor conditions before planting them in your garden.
This seed-based reproduction method allows for a wider variety of petunia cultivars to be cultivated, from the classic grandiflora types with their large, ruffled blooms to the compact multiflora varieties ideal for hanging baskets.
The absence of spores in petunia reproduction has significant implications for their genetic diversity. Unlike ferns, which can reproduce asexually through spores, petunias rely on sexual reproduction, requiring pollination for seed production. This process involves the transfer of pollen from the male anther to the female stigma, typically facilitated by insects like bees and butterflies. Encouraging pollinators in your garden by planting companion flowers like marigolds or lavender can enhance petunia seed production and contribute to a healthier ecosystem.
While petunias don't produce spores, they share a common vulnerability with spore-producing plants: susceptibility to fungal diseases. Powdery mildew, a common issue for petunias, thrives in humid conditions and can be mitigated by ensuring good air circulation around the plants and avoiding overhead watering. Regularly inspecting your petunias for signs of disease and promptly removing affected leaves can prevent the spread of fungal pathogens.
By understanding the unique reproductive methods of petunias and their specific needs, gardeners can cultivate thriving displays of these colorful flowers, enjoying their beauty throughout the growing season.
Can Mold Spores Cause Cancer? Uncovering the Hidden Health Risks
You may want to see also

Seed vs. Spore Differences: Seeds contain embryos; spores are single-celled reproductive units
Petunias, like most flowering plants, reproduce through seeds, not spores. This fundamental distinction hinges on the presence of an embryo within the seed, a feature absent in spores. Seeds are complex structures housing a miniature plant—the embryo—along with stored nutrients to support germination. Spores, in contrast, are simple, single-celled units that rely on favorable conditions to grow directly into new organisms. Understanding this difference clarifies why petunias, as seed-producing plants, lack spores entirely.
Consider the reproductive strategies of plants and fungi to grasp this disparity further. Seeds are characteristic of angiosperms (flowering plants) and gymnosperms (cone-bearing plants), which invest energy in protecting and nourishing their embryos. Spores, however, are the domain of ferns, mosses, and fungi, which disperse vast numbers of these lightweight cells to colonize new environments. For petunias, seed production ensures genetic continuity through a protected, nutrient-rich package, while spores’ simplicity allows for rapid, widespread dispersal in other organisms.
From a practical standpoint, gardeners can leverage this knowledge to propagate petunias effectively. Seeds require specific conditions—adequate moisture, warmth, and light—to germinate, typically within 10–14 days. Spores, if they were present, would demand entirely different handling, often needing sterile environments to prevent contamination. Since petunias rely on seeds, focus on providing well-draining soil, consistent watering, and a temperature range of 70–75°F (21–24°C) for optimal seedling growth.
The absence of spores in petunias also highlights their evolutionary adaptation to flowering plant biology. While spores excel in harsh or unpredictable environments, seeds offer a survival advantage in stable ecosystems by ensuring offspring have a head start. Petunias’ vibrant blooms and prolific seeding reflect this strategy, making them a staple in gardens worldwide. By understanding the seed-spore dichotomy, gardeners can better appreciate the unique reproductive mechanisms that define these beloved plants.
Can Mold Spores Get on Clothes? Understanding Risks and Prevention
You may want to see also

Petunia Life Cycle: Petunias grow from seeds, flower, and produce new seeds annually
Petunias, unlike ferns or fungi, do not produce spores. Instead, their life cycle is entirely seed-based, a characteristic that places them firmly in the angiosperm (flowering plant) category. This annual process begins with germination, where a tiny seed, no larger than a pinhead, absorbs water and nutrients from the soil, cracking open to send a root downward and a shoot upward. Within 7 to 14 days, under optimal conditions of warmth and moisture, the seedling emerges, displaying its first set of true leaves. This stage is critical; young petunias are sensitive to cold and require consistent watering to establish a strong root system.
As the plant matures, it enters the vegetative phase, focusing on leaf and stem growth. During this period, gardeners can encourage bushier plants by pinching back the growing tips, a technique that promotes lateral branching. By late spring, the petunia shifts its energy toward flowering, producing vibrant blooms in a spectrum of colors. This transition is triggered by longer daylight hours and warmer temperatures, signaling the plant to reproduce. The flowers, which can last from late spring until the first frost, are not just ornamental; they are the precursors to seed production.
Pollination is the next critical step in the petunia’s life cycle. While petunias are self-fertile, meaning they can pollinate themselves, they benefit from the assistance of bees, butterflies, or even wind. Once pollinated, the flower begins to wither, and the ovary at its base swells, developing into a seed capsule. This capsule, often overlooked in favor of the showy blooms, is the key to the plant’s annual renewal. As the capsule matures, it dries and splits open, releasing dozens of tiny seeds into the surrounding soil.
For gardeners looking to collect petunia seeds, timing is crucial. Harvest the capsules just before they fully open, as seeds can be lost if left too long. Place the capsules in a paper bag and store them in a cool, dry place for a week to ensure they are fully dry. Once dry, gently crush the capsules to release the seeds, which can then be stored in an airtight container for planting the following season. This method not only saves money but also allows gardeners to preserve specific varieties or colors they particularly admire.
Understanding the petunia’s seed-based life cycle highlights its adaptability and resilience. Unlike spore-producing plants, which rely on moisture and specific environmental conditions for reproduction, petunias thrive in a wide range of climates, from full sun to partial shade. Their annual cycle ensures that even if the parent plant dies with the first frost, its genetic legacy continues through the seeds left behind. This makes petunias not just a favorite for seasonal color but also a fascinating example of nature’s efficiency in ensuring survival through simple, yet effective, reproductive strategies.
Mold Spores and Sore Throats: Uncovering the Hidden Connection
You may want to see also
Explore related products
$5.99

Spores in Plants: Spores are common in non-flowering plants like mosses and ferns
Spores are nature’s ingenious solution for plant survival, particularly in non-flowering species like mosses and ferns. Unlike seeds, which contain a miniature plant encased in protective layers, spores are single-celled reproductive units capable of developing into new organisms under favorable conditions. This simplicity allows them to disperse widely—carried by wind, water, or animals—and endure harsh environments, from arid deserts to dense forests. For gardeners or botanists curious about petunias, understanding spores highlights the stark contrast between flowering and non-flowering plant reproduction, as petunias rely on seeds, not spores, to propagate.
Consider the life cycle of a fern to grasp the role of spores in plant reproduction. Ferns produce spores on the undersides of their fronds, often visible as small, brown dots. When released, these spores germinate into tiny, heart-shaped structures called prothalli, which grow in moist, shaded areas. The prothalli then produce gametes that, after fertilization, develop into new ferns. This process, known as alternation of generations, showcases the efficiency of spores in ensuring species continuity. In contrast, petunias bypass this complexity, producing seeds directly from flowers, a trait common in flowering plants.
For those cultivating non-flowering plants like mosses, understanding spore dispersal is key to successful propagation. Moss spores require specific conditions—high humidity, indirect light, and a sterile substrate—to germinate. A practical tip: mix moss spores with buttermilk or yogurt (a natural adhesive) and spread the mixture on soil or stone surfaces. This method mimics the sticky texture of moss colonies and enhances spore adherence. While petunias demand seed-starting techniques like sowing in trays and thinning seedlings, mosses thrive through spore-based methods, underscoring the diversity of plant reproductive strategies.
The comparative study of spores and seeds reveals evolutionary adaptations to environmental challenges. Spores, lightweight and resilient, are ideal for plants in unstable habitats, such as mosses in rocky terrains or ferns in humid forests. Seeds, however, offer protection and nutrient reserves, suiting flowering plants like petunias that grow in more predictable conditions. For educators or hobbyists, demonstrating this contrast through side-by-side experiments—growing moss from spores versus petunias from seeds—can illustrate the brilliance of nature’s design. While petunias will never produce spores, exploring spore-bearing plants enriches our appreciation of botanical diversity.
Freezing Athlete's Foot Spores: Effective Treatment or Myth?
You may want to see also

Why Petunias Lack Spores: Petunias are angiosperms, relying on seeds for propagation, not spores
Petunias, with their vibrant blooms and cascading growth, are a staple in gardens worldwide. Yet, despite their popularity, a common misconception lingers: do they reproduce via spores? The answer lies in their botanical classification. Petunias are angiosperms, a group of plants characterized by their production of flowers and seeds. Unlike ferns or fungi, which rely on spores for propagation, angiosperms have evolved a more complex reproductive strategy centered around seeds. This fundamental difference explains why petunias lack spores entirely.
To understand why petunias don’t produce spores, consider their life cycle. Angiosperms like petunias undergo double fertilization, a process unique to this group. One sperm fertilizes the egg to form the embryo, while the other fuses with the central cell to create the endosperm, a nutrient-rich tissue that nourishes the developing seed. This intricate process results in the formation of seeds encased in protective structures, such as fruits or pods. Spores, on the other hand, are haploid cells produced by simpler organisms like ferns or mosses, which can develop into new individuals without fertilization. Petunias bypass this primitive method, relying instead on the genetic diversity and protection offered by seeds.
From a practical gardening perspective, understanding that petunias propagate via seeds has direct implications for cultivation. Gardeners can collect seeds from mature petunia plants at the end of the growing season, typically in late summer or early fall. To do this, allow the flower to wither and the seed pod to dry on the plant. Once the pod turns brown and begins to split, gently remove the seeds and store them in a cool, dry place. When planting, sow the seeds indoors 8–10 weeks before the last frost, using a seed-starting mix and maintaining a temperature of 70–75°F (21–24°C) for optimal germination. This seed-based approach ensures continuity in your garden while aligning with the natural reproductive mechanisms of petunias.
Comparatively, plants that rely on spores, such as ferns, require different care and propagation techniques. Spores are microscopic and often dispersed by wind, making them less controllable than seeds. In contrast, petunia seeds are larger, more durable, and easier to handle, making them ideal for home gardeners. Additionally, seeds allow petunias to adapt genetically over generations, increasing their resilience to environmental changes. This adaptability is a key advantage of angiosperms over spore-producing plants, which often lack the same level of genetic diversity.
In conclusion, petunias’ absence of spores is a direct result of their classification as angiosperms, a group that has evolved to prioritize seed-based reproduction. This method not only ensures the survival and spread of the species but also offers practical benefits for gardeners. By focusing on seed collection and propagation, enthusiasts can cultivate petunias year after year, appreciating both their beauty and the sophistication of their reproductive strategy. Understanding this distinction clarifies why spores play no role in the life cycle of petunias, reinforcing their place as quintessential flowering plants.
Can Botulism Spores Be Deadly? Uncovering the Lethal Truth
You may want to see also
Frequently asked questions
No, petunias do not have spores. They are flowering plants that reproduce through seeds.
Petunias reproduce through seeds, which are produced after pollination of their flowers.
No, spores are not involved in a petunia’s life cycle. They rely entirely on seeds for reproduction.
Plants like ferns, mosses, and fungi reproduce using spores, not seeds.
No, petunias cannot be grown from spores. They must be grown from seeds or propagated through cuttings.